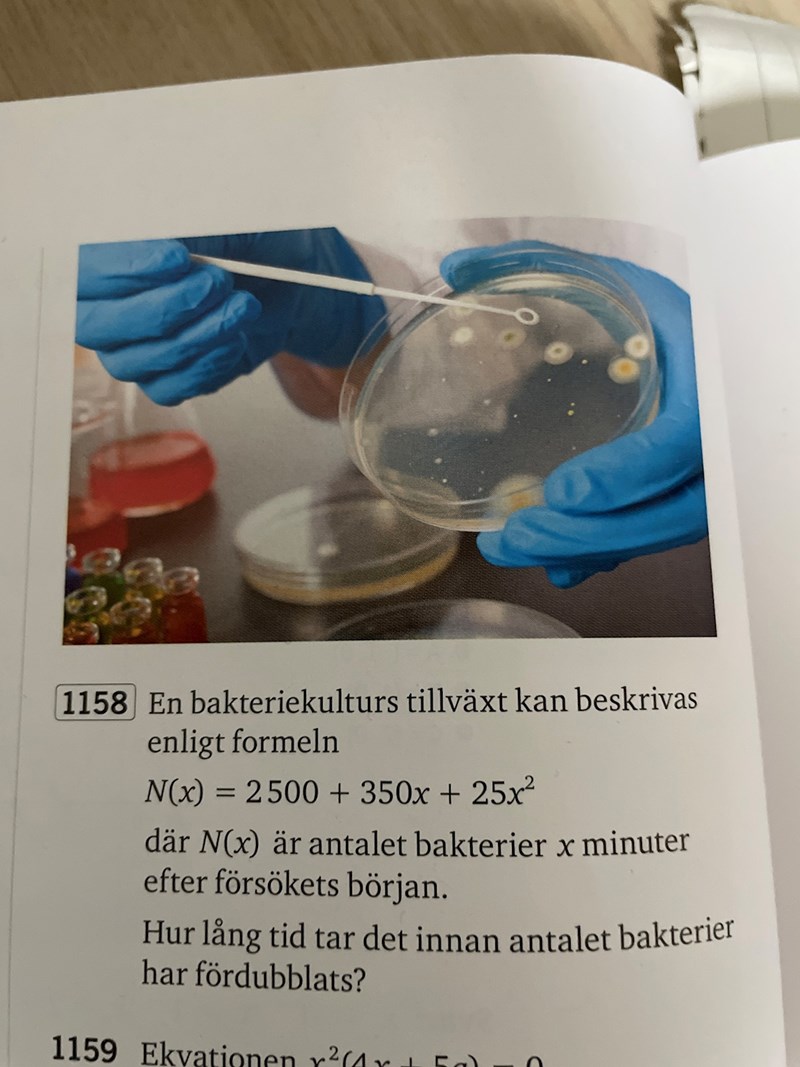

1
svar
51
visningar
Vad är det första steget?
Jag lyckas inte lista ut vad jag ska börja med för att lösa uppgiften, testade att förenkla uttrycket men det leder mig ingenstans.
Jag lyckas inte lista ut vad jag ska börja med för att lösa uppgiften, testade att förenkla uttrycket men det leder mig ingenstans.
Börja med att bestämma N(0) dvs hur många som finns från början!


